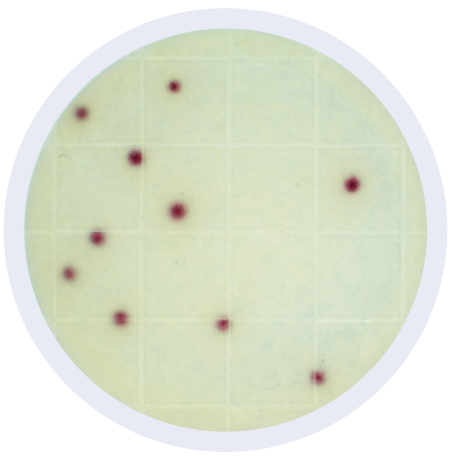

Las placas Peel Plate CC utilizan un medio EC convencional con sustratos enzimáticos productores de color formando colonias rojas.
- Recupera un 25% más de cepas de Coliformes que los métodos de la competencia.
- No se requiere interpretación de gas / ácido
- Aprobado para su uso con NCMIS / PMO y FDA 2400
- Contamos con la Placa Peel Plate CC Cultured Dairy (productos lácteos), y la placa Peel Plate CCHV (High Volume) disponibles para muestras de 5ml.
Beneficios
- Simplemente agregue la muestra / dilución. No se necesita de accesorios para difundir la muestra (difusor)
- Cuenta con cuadrículas grabadas para recuentos estimados.
- Las colonias se recogen fácilmente para posterior aislamiento/clasificación.
- Las placas están diseñadas para apilarse una encima de otra, con el objetivo de maximizar el espacio.
- Formulación buffer, no es necesario el ajuste del pH para la mayoría de las muestras.
- Vida útil de hasta 12 meses a temperatura ambiente o en refrigeración, cuenta con una bolsa de aluminio con cierre hermético “zip”.
- 47 mm de diámetro conveniente para muestras líquidas filtradas de 100 ml o más, como agua, vino y bebidas.
- Rendimiento robusto con buffers neutralizantes utilizados en muestras de superficies ambientales.
Procedimiento
1

Levante
2

Pipetee verticalmente
3

Selle
Charm Peel Plate
Las pruebas Charm Peel Plate son placas microbianas de métodos de cultivo simplificados para la detección de microorganismos, cuentan con la certificación de la AOAC-RI en donde se garantiza el desempeño de las pruebas AC (Aerobios), EC (E-coli coliformes), YM (Mohos y Levaduras). Asi como también la prueba EB, (Enterobacterias), recibió la certificación MicroVal armonizada con la AOAC en “The Official Method of Analysis First Action Status”.
Para alimentos lácteos las pruebas Charm Peel Plate AC (Aerobios), CC (Coliformes), EC (E-coli coliformes) y Cultured dairy CC y EC cuentan con la aprobación FDA/NCIMS.

Las pruebas de Peel Plate se utilizan en productos lácteos, carnes molidas, otros alimentos, superficies ambientales de contacto y agua. Peel Plate cuenta con pruebas de 1 ml de volumen, para bacterias aeróbicas (prueba Peel Plate AC), recuento heterotrófico (prueba Peel Plate HET) y Staphylococcus Aureus (prueba Peel Plate SA). También cuenta con pruebas de 1 ml y 5 ml (High Volume) para el recuento de coliformes (prueba Peel Plate CC), coliformes / E. coli (prueba Peel Plate EC), enterobacteriaceae (prueba Peel Plate EB) y levaduras y mohos (prueba Peel Plate YM
